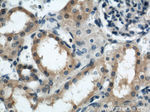
ARL13B Antibody in Immunohistochemistry (Paraffin) (IHC (P))

Search
Proteintech
ARL13B Polyclonal Antibody
{{$productOrderCtrl.translations['antibody.pdp.commerceCard.promotion.promotions']}}
{{$productOrderCtrl.translations['antibody.pdp.commerceCard.promotion.viewpromo']}}
{{$productOrderCtrl.translations['antibody.pdp.commerceCard.promotion.promocode']}}: {{promo.promoCode}} {{promo.promoTitle}} {{promo.promoDescription}}. {{$productOrderCtrl.translations['antibody.pdp.commerceCard.promotion.learnmore']}}
图: 1 / 20
ARL13B Antibody (17711-1-AP) in ICC/IF

产品信息
17711-1-AP
种属反应
已发表种属
宿主/亚型
分类
类型
抗原
偶联物
形式
浓度
规格
纯化类型
保存液
内含物
保存条件
运输条件
产品详细信息
This antibody detects two specific bands at 60 kDa and 48 kDa. Arl13b is predicted to be a 48 kDa protein, and the 60 kDa band is likely to represent a modified form of Arl13b. ARL13B can be used to mark the cilia.
Immunogen sequence: MFSLMASCC GWFKRWREPV RLANKQDKEG ALGEADVIEC LSLEKLVNEH KCLCQIEPCS AISGYGKKID KSIKKGLYWL LHVIARDFDA LNERIQKETT EQRALEEQEK QERAERVRKL REERKQNEQE QAELDGTSGL AELDPEPTNP FQPIASVIIE NEGKLEREKK NQKMEKDSDG CHLKHKMEHE QIETQGQVNH NGQKNNEFGL VENYKEALTQ QLKNEDETDR PSLESANGKK KTKKLRMKRN HRVEPLNIDD CAPESPTPPP PPPPVGWGTP KVTRLPKLEP LGETHHNDFY RKPLPPLAVP QRPNSDAHDV IS (1-321 aa encoded by BC094725)
靶标信息
This gene encodes a member of the ADP-ribosylation factor-like family. The encoded protein is a small GTPase that contains both N-terminal and C-terminal guanine nucleotide-binding motifs. This protein is localized in the cilia and plays a role in cilia formation and in maintenance of cilia. Mutations in this gene are the cause of Joubert syndrome 8. Alternate splicing results in multiple transcript variants.
仅用于科研。不用于诊断过程。未经明确授权不得转售。
生物信息学
蛋白别名: ADP ribosylation factor like GTPase 13B; ADP-ribosylation factor-like 2-like 1; ADP-ribosylation factor-like protein 13B; ADP-ribosylation factor-like protein 2-like 1; ARL2-like protein 1; Protein hennin; unnamed protein product
基因别名: A530097K21Rik; A930014M17Rik; ARL13B; ARL2L1; C530009C10Rik; hnn; JBTS8
UniProt ID: (Human) Q3SXY8, (Mouse) Q640N2
Entrez Gene ID: (Dog) 487934, (Human) 200894, (Rat) 304037, (Mouse) 68146




